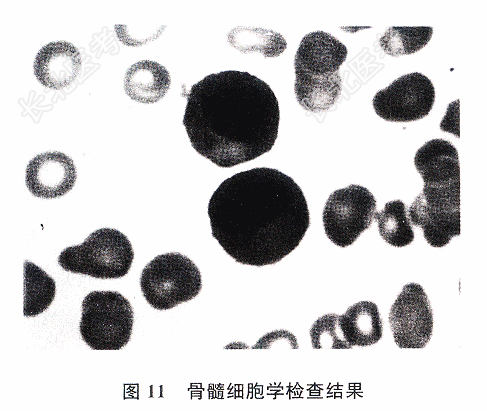

试题详情
- [材料题] 患者,女,51岁,因“上腹部疼痛伴恶心,呕吐1个多月,加重1周”入院。查体:生命征平稳,一般情况差,消瘦,贫血貌,胸骨压痛,心肺腹无明显异常,腰椎叩痛。X线:肋骨病理性骨折,腰椎、肋骨、骨盆多处溶骨性改变。血常规:WBC6.3×10⁹/1,Hb64g/L,PLT108×10⁹/L。血生化:Urea7.85mmol/L,Ca2.57mmol/L,P3.02mmol/L,TP66.3g/L,ALB39g/L。免疫:IgG3.35g/L(参考值8~15.5g/L),IgA190mg/L(参考值836~2900mg/L),IgM270mg/L(参考值700~2200mg/L)。骨髓细胞学:有核细胞增生活跃,浆细胞占18%,幼稚浆细胞占2%(图11)。
- 简答题1、该患者最可能的初步诊断是?
关注下方微信公众号,搜题查看答案

- 简答题2、为明确诊断首选的检查是?
关注下方微信公众号,搜题查看答案

热门试题
- 1、临床常用来诊断溶血的指标是?2、此时
- 1、此时需做哪些必要的检查?2、临床常用
- 1、该患者最可能的诊断是?2、若该患者尿
- 1、患者可能的诊断为?2、提示:入院体格
- 1、该患者可诊断为?2、抗核抗体阳性对诊
- 1、HLA是决定移植手术是否成功的主要因
- 1、诊断首先考虑为?2、最有助于确定诊断
- 1、该患者最可能的初步诊断是?2、为明确
- 1、最可能的诊断是?2、明确诊断应做的检
- 1、该患者最可能的临床诊断是?2、多发性
- 1、根据上述信息,该病例的诊断是?2、对
- 1、若要判断患儿T淋巴细胞功能,应选择?
- 1、此时鉴别诊断肝癌需做哪些必要实验室检
- 1、为明确诊断首选的检查是?2、该患者最
- 1、辅助诊断非小细胞肺癌的首选肿瘤标志物
- 1、该患者除骨折外,首先考虑的疾病是?2
- 1、为鉴别诊断肝癌和某些非恶性肝脏病变,
- 1、本例临床类型是?2、钩端螺旋体病主要
- 1、本例病人如果有肺水肿,则首要的措施是
- 1、该患儿发生的超敏反应类型为?2、血清